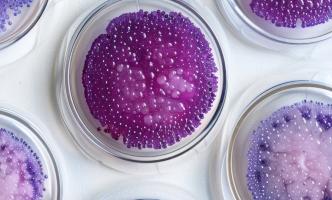
C'est la découverte d'un régulateur génétique qui améliore la santé des plantes (Visuel Adobe Stock 785712765)

Vous recherchez une actualité ou un dossier
Recherche (liste)
Mode d'affichage :
-
RÉGIME VÉGÉTARIEN : Adapté aussi à l’Enfant ?
Actualité publiée le 19/02/2026PLANETARY HEALTH DIET et régime méditerranéen : Idem pour la planète, idem pour la santé
Actualité publiée le 21/01/2026
-
MICROPLASTIQUES : Comment ils finissent dans nos assiettes
Actualité publiée le 21/12/2025ÉCOSYSTÈME : Préserver le cycle de l’eau ou l’évapotranspiration de la planète
Actualité publiée le 12/11/2025
-
ÉDITION du GÉNOME : Inspirée par les stratégies de défense des bactéries
Actualité publiée le 25/09/2025PROTÉINES VÉGÉTALES : Supérieures aux protéines animales ?
Actualité publiée le 20/09/2025
-
PHYTOTHÉRAPIE : Bonne pour l’esprit aussi
Actualité publiée le 23/08/2025CANCER de l’ESTOMAC : Sur le potentiel inexploré de la phytothérapie
Actualité publiée le 14/08/2025
-
TABAGISME : Les 3 moyens les plus efficaces selon la science d’arrêter de fumer
Actualité publiée le 07/08/2025THYROÏDE, anxiété et dépression : La phytothérapie aide aussi
Actualité publiée le 05/05/2025
-
POLLUTION : Les microplastiques démultiplient l'effet des autres polluants
Actualité publiée le 19/03/2025SURVEILLANCE ENVIRONNEMENTALE : Utiliser les plantes ou les animaux pour détecter les toxiques
Actualité publiée le 12/03/2025
-
Les MICROBIOMES à l’honneur, avec la biologie des holobiontes
Actualité publiée le 30/01/2025ALIMENTATION : Moins de glucides, toujours moins de poids à long terme
Actualité publiée le 19/01/2025
-
RAM : Un composé végétal et naturel contre le biofilm
Actualité publiée le 15/01/2025PARKINSON : Les promesses prophylactiques des antioxydants des algues
Actualité publiée le 21/09/2024
-
NITRATES ALIMENTAIRES : D’origine végétale ou d’origine animale, des effets contraires
Actualité publiée le 08/09/2024URTICAIRE : Une feuille de laitue contre la piqûre d’ortie ?
Actualité publiée le 03/08/2024
-
LAVANDE : Ce gène régulateur protecteur et parfumeur
Actualité publiée le 10/07/2024RÉGIME VÉGÉTARIEN : 20 années de preuves de ses bienfaits
Actualité publiée le 17/06/2024
-
TRANSPLANTATION CARDIAQUE chez l’ENFANT : Mieux comprendre son rejet
Actualité publiée le 07/03/2024ALIMENTATION : Pourquoi il faut mieux dire « durable » que « végétalien »
Actualité publiée le 17/01/2024
-
CANCER du SEIN : Quelle efficacité des composés naturels du soja ?
Actualité publiée le 14/01/2024FLAVONOÏDES : Le secret de leurs bienfaits pour la santé
Actualité publiée le 08/01/2024
-
DÉCLIN COGNITIF : Une préparation médicinale qui rebooste la santé cérébrale
Actualité publiée le 10/11/2023TROUBLES POLY-Q : Les chloroplastes détiennent-ils la clé ?
Actualité publiée le 30/10/2023
-
GINGEMBRE : Kencur vs cancer
Actualité publiée le 28/09/2023DIABÈTE : L’administration orale d'insuline végétale qui évite l’hypoglycémie
Actualité publiée le 11/07/2023
-
RÉGIME VÉGÉTARIEN : Meilleur pour nos artères, meilleur pour la planète
Actualité publiée le 04/07/2023DISPOSITIFS, PANSEMENTS : Une super-mousse antimicrobienne à l'effet lotus
Actualité publiée le 05/05/2023
-
DIABÈTE : Le régime végétarien confirme ses bénéfices
Actualité publiée le 31/03/2023COVID-19 : Des extraits de plantes qui bloquent le SARS-CoV-2
Actualité publiée le 15/02/2023
-
CANCER du POUMON : Les promesses antimutagènes du jus d'Actinidia arguta
Actualité publiée le 22/01/2023CANCER du SEIN : Un supplément nutritionnel contre la tumeur ?
Actualité publiée le 15/09/2022
Pages